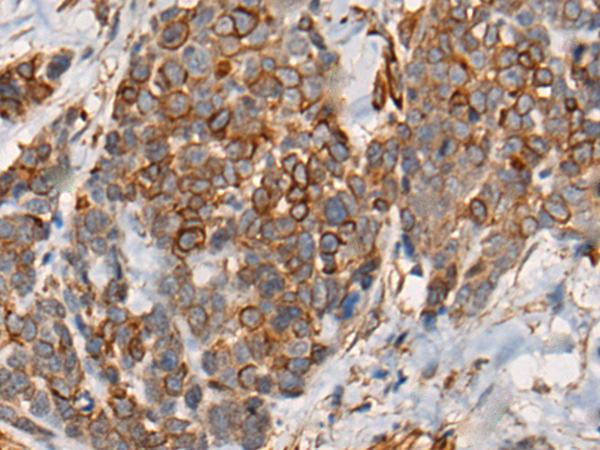

-
分类: 科研抗体货号: P13018别名: GP180应用: IHC反应种属: Human
-
分类: 科研抗体货号: P13019别名: CARMIL; LRRC16; LRRC16A; CARMIL1a; dJ501N12.1; dJ501N12.5应用: IHC反应种属: Human, Mouse
-
分类: 科研抗体货号: P13017别名: PKACA; PPNAD4应用: WB,IHC反应种属: Human, Mouse, Rat
-
分类: 科研抗体货号: P13035别名: V7; IGSF2; EWI-101应用: WB,IHC反应种属: Human, Rat
-
分类: 科研抗体货号: P13015别名: CAMKA应用: IHC反应种属: Human, Mouse, Rat
-
分类: 科研抗体货号: P13034别名: P42; CCRK; CDCH; PNQALRE应用: IHC反应种属: Human, Mouse, Rat
-
分类: 科研抗体货号: P13014别名: GC36; nCL-4应用: IHC反应种属: Human, Mouse, Rat
-
分类: 科研抗体货号: P13033别名:应用: IHC反应种属: Human
-
分类: 科研抗体货号: P13013别名: SOLH应用: WB,IHC反应种属: Human, Mouse
-
分类: 科研抗体货号: P13032别名: ALP; ILC; CTAK; CTACK; PESKY; ESKINE; SCYA27应用: IHC反应种属: Human

鄂公网安备42018502007531号
鄂公网安备42018502007531号

